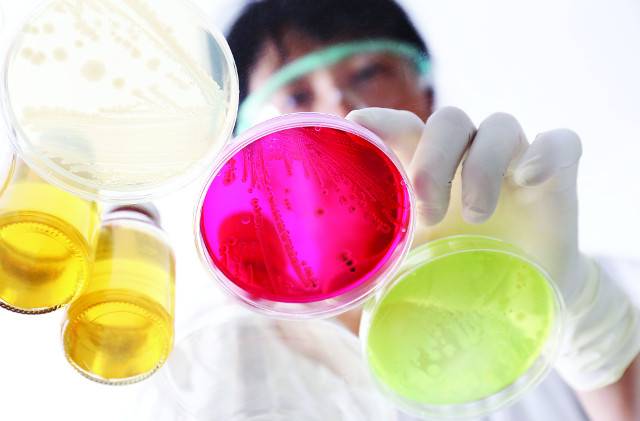
게티이미지뱅크

[And 건강] 전체 병원에 만연된 항생제 내성균… CRE, 무서운 확산세
관리 소홀·항생제 오남용 등 원인
범부처 대책 시행, 성과는 미지수
전문가 “계획 이행 제대로 안 돼
사업 전반 면밀한 점검·평가 필요”
"항생제 내성균은 이제 특정 지역에서의 유행(epidemic)을 넘어 전체 병원에 만연돼 있고 제대로 관리되지 않고 있다는 게 문제다. 특히 카바페넴 내성 장내세균(CRE)의 확산세가 무섭다."
수도권 대학병원의 감염내과 A교수는 국내 항생제 다제내성균 확산의 심각성에 대해 최근 이렇게 밝혔다. 다제내성균은 여러 항생제 치료에 반응하지 않는 세균을 말한다. CRE는 현존 최고인 카바페넴 계열 항생제에도 듣지 않아 이른바 '슈퍼 박테리아'로 불린다. 세계보건기구(WHO)는 2024년 보고서에서 CRE를 '공중보건 조치의 우선순위가 가장 높은 병원체'로 지목했다.
A교수는 “장기 입원하거나 입·퇴원을 반복하는 환자들의 CRE 감염 위험이 크고 특히 혈액 감염이나 폐렴이 동반되면 치명률이 70%에 달한다”고 말했다.

국내 CRE 감염증 신고는 2017년 6월 전수 감시 대상인 2급 감염병 지정 이후 매년 급증하는 추세다. 3일 질병관리청 감염병 포털에 따르면 지난해 4만2851건의 CRE 감염증 발생이 신고돼 전년(3만8405건)보다 11.6% 증가했다. 첫 연간 통계가 있는 2018년(1만1954건)에 비하면 3.58배 늘었다. 올해도 벌써 2437건(2월 2일 기준)이 발생했다. CRE 사망자도 2018년 143명에서 2023년 661명으로 4.6배가량 증가했다.
전문가들은 코로나19 대유행으로 인한 의료자원의 부족, 감염관리 소홀, 항생제 사용 증가 등을 최근 몇 년새 CRE 감염 심화의 원인으로 지목한다. CRE는 주로 감염 환자나 그 주변 환경과의 직간접 접촉으로 전파된다. 장기 입원환자, 면역 억제제 투여자, CRE 감염력이 있는 경우 발생 위험이 높다.
CRE 중 특히 카바페넴 분해 효소를 생성하는 유형(CP-CRE)이 내성 유전자를 다른 세균으로 빠르게 전파해 집단감염을 일으킨다. 질병청이 최근 공개한 2023년 CRE 감염증 신고 현황 분석에 따르면 전체 3만8405건 중 CP-CRE 비율이 73.7%를 차지했다. CP-CRE 비중은 2019년 57.8%, 2020년 61.9%, 2021년 63.4%, 2022년 71.0%로 해마다 증가 추세다.
노인 인구 및 요양병원 등 의료기관 이용 증가, 항생제 오남용과 무관치 않다는 분석이다. 2023년 CRE 감염증 신고자의 84%가량이 60세 이상이었다. 의료기관별로는 종합병원(43%) 상급종합병원(35%) 요양병원(15.1%) 병원(5.5%) 순으로 많았다. 특히 요양병원의 CRE 신고는 2019년 7%에서 2023년 15.1%로 배 이상 증가해 적극적인 관리책 마련이 필요함을 시사한다.
요양병원 환자는 고령의 만성질환자가 많고 밀집된 공간에 장기 입원함으로써 요로감염 등 각종 감염에 취약해 항생제를 자주 사용하게 된다. 하지만 항생제의 부적절한 사용이 많아 내성 발생 위험이 높다.

실제 질병청이 2020~2022년 의료기관별 환자 1000명 당 하루 표준 항생제 평균 사용량(DID)을 조사한 결과 요양병원이 27.5DID로, 의원(17.0DID) 상급종합병원(10.6DID) 종합병원(9.8DID) 병원(8.5DID)보다 월등히 많았다. 더구나 2020년 대비 2022년 항생제 사용량은 상급종합병원(3.7%)과 종합병원(6.4%)에서 감소했으나 요양병원(10%)과 의원(19.4%) 병원(5.5%)은 오히려 증가했다. 또 전국 1764개 요양병원과 139만명의 입원 환자를 조사했더니 항생제 사용자의 처방 적정성은 35.2%에 그쳤다. 즉 요양병원 항생제 처방 환자 10명 중 6명꼴(64.8%)로 부적절했다는 얘기다.
질병청 조사에선 요양병원뿐만 아니라 병·의원의 항생제 사용도 증가하는 것으로 나타났다. 이에 따라 이들 1차 의료기관부터 항생제의 적정 사용과 내성 감시·관리가 철저히 이뤄져야 한다는 지적이 나온다. 최근 대한요로생식기감염학회 주최 국회 토론회에선 항생제 다제내성균에 의한 요로감염에 대한 통합적 대응 방안이 논의됐다.
요로감염은 여성의 약 50%, 남성의 10% 정도가 평생 한 번 이상 경험한다. 주요 원인균인 장내세균을 완전히 제거하기 어려워 환자의 약 25%가 재발을 경험한다. 치료 시 항생제 사용은 필수다. 임동훈 생식기요로감염학회장은 “미국 유럽에서도 요로감염 치료에 전체 항생제 사용량의 15%가 쓰일 정도로 빈번하다”면서 “하지만 항생제의 과도한 사용은 다제내성균의 발생을 촉진한다. 최근 슈퍼 박테리아의 약 60%가 장내세균에서 비롯되고 대부분 요로감염과 밀접한 관련이 있다”고 지적했다.
이런 문제를 해결하려면 요로감염 환자의 항생제 사용 관리와 지역별 내성 감시체계 확립이 꼭 필요한데, 현재 1·2차 의료기관에선 미흡한 실정이다. 비뇨의학과 개원의인 민승기 원장은 특히 1차 의료기관에서의 항생제 사용 관리가 중요하다고 강조했다. 민 원장은 “요로감염 환자의 대부분이 의원급에서 진료받고 있으며 요로감염의 초기 단계이자 경증 질환인 급성 방광염 환자에게서의 효율적인 항생제 사용이 다제내성균 관리의 첫걸음”이라고 강조했다.
민 원장은 “일부 의원에서 여전한 항생제 오남용, 처방대로 약물을 복용하지 않는 환자의 순응도 문제 등이 작용하는 것 같다”면서 “심평원의 적극적인 모니터링, 1차 기관 진료 의사의 교육, 적극적인 환자 교육 등 다양한 방법이 강구돼야 한다”고 부연했다.
정부는 2016년부터 항생제 내성 문제 해결을 위해 범부처 중장기 관리 대책을 마련하고 현재 2차 계획(2021~2025년)을 시행 중이다. 지난해 11월엔 300병상 넘는 종합병원 이상 의료기관 대상으로 ‘항생제 적정 사용 관리(ASP)’ 시범사업에 들어갔으나 성과가 있을지는 미지수다.
한 대학병원 감염내과 교수는 “중간에 코로나19 대유행의 영향을 감안하더라도 정부의 2주기 항생제 내성 관리 대책은 실패했다고 봐야 한다. 목표했던 5개 지표가 제대로 이행된 게 없다. 왜 실패했는지에 대한 면밀한 평가가 있어야 한다”고 쓴소리를 했다.
배상락 가톨릭의대 의정부성모병원 비뇨의학과 교수는 “WHO의 2050년 주요 사망 원인 예측에서 항생제 내성균이 1000만명으로 암(820만명)을 제치고 1위에 오를 거로 추정됐다”면서 “요로감염에 취약한 고령자, 저소득층, 소아 등에 대한 항생제 내성 관리에 더욱 신경 쓰고 관련 예산의 대폭 확대가 따라야 한다”고 말했다. 아울러 의료기관 종별 맞춤형 항생제 내성 관리 방안 마련, 비항생제 치료법 및 새로운 환경소독 기술 개발 등도 시급하다는 지적이다.
민태원 의학전문기자 twmin@kmib.co.kr
GoodNews paper ⓒ 국민일보(www.kmib.co.kr), 무단전재 및 수집, 재배포 및 AI학습 이용 금지
Copyright © 국민일보. 무단전재 및 재배포 금지.
- 민주 박선원 “트럼프, 노벨평화상 후보로 추천”
- 윤여정 비하했던 트랜스젠더 배우, 오스카 후보 되자 사과
- 꽁꽁 얼어붙은 경기… 취준생 55% “붙으면 어디든 가겠다”
- ‘시골 아이들 교육이···’ 한마디에 벌어진 일[아살세]
- 노화와 출산 후 나타나는 요실금, 치료법과 예방법은?
- “내가 MBC 나올 때도”… 배수연 기상캐스터 ‘오요안나’ 사건 언급
- 한계 맞은 ‘백종원 의존증’… 빽햄 등 악재에 주가 연일 최저가
- 올해 더 건강하게 ‘다짐 소비’ 뜬다
- [단독] 주식 상담했더니 “코인이 유망”… 전액 날린 선물 투자 사기
- 예금 금리 더 받으려면 ‘3년’보다 ‘6개월’